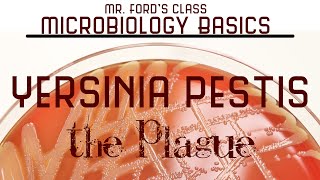

Yersinia pestis The Plague : Microbiology Lectures video
Online izle ve mp4 mp3 formatlarinda yukle

Videonun muddeti: 15:25
Yersinia pestis The Plague : Microbiology Lectures videosu mp4 ve mp3 yuklemek ucun hazirdir
Diqqet! Siz Mp4 yukle ve ya Mp3 yukle duymesine basdiqdan sonra eger sistem sizi reklam sehifesine atarsa o zaman derhal geri qayidib emeliyyati tekrar edin ve faylin yuklemek ucun hazir olmasini gozleyin
Videodan Mp4 Yukle
Videodan Mp3 Yukle-1
Videodan Mp3 Yukle-2
Oxshar Axtarishlar
 Yersinia pestis - The Plague : Microbiology Lectures
Yersinia pestis - The Plague : Microbiology Lectures The Plague: Yersinia pestis
The Plague: Yersinia pestis Plague (Yersinia pestis) in 3 Minutes
Plague (Yersinia pestis) in 3 Minutes Yersinia Pestis & Yersinia Enterocolitica for the USMLE Step 1
Yersinia Pestis & Yersinia Enterocolitica for the USMLE Step 1 Yersinia pestis
Yersinia pestis Yersinia pestis | Microbiology | Handwritten notes
Yersinia pestis | Microbiology | Handwritten notes Yersinia pestis bacillus | bubonic plague bacteria | Yersinia pestis pathogenesis
Yersinia pestis bacillus | bubonic plague bacteria | Yersinia pestis pathogenesis Plague (Yersinia pestis) and Y. enterocolitica USMLE Step 1 2021 Microbiology lecture 25 page 144
Plague (Yersinia pestis) and Y. enterocolitica USMLE Step 1 2021 Microbiology lecture 25 page 144 Plague 101 | National Geographic
Plague 101 | National Geographic
Video Mp4 Mp3Azwap.Biz
Azwap.Biz 2021-2023

Yersinia pestis - The Plague : Microbiology Lectures
Yersinia pestis - The Plague : Microbiology Lectures The Plague: Yersinia pestis
The Plague: Yersinia pestis Plague (Yersinia pestis) in 3 Minutes
Plague (Yersinia pestis) in 3 Minutes Yersinia Pestis & Yersinia Enterocolitica for the USMLE Step 1
Yersinia Pestis & Yersinia Enterocolitica for the USMLE Step 1 Yersinia pestis
Yersinia pestis Yersinia pestis | Microbiology | Handwritten notes
Yersinia pestis | Microbiology | Handwritten notes Yersinia pestis bacillus | bubonic plague bacteria | Yersinia pestis pathogenesis
Yersinia pestis bacillus | bubonic plague bacteria | Yersinia pestis pathogenesis Plague (Yersinia pestis) and Y. enterocolitica USMLE Step 1 2021 Microbiology lecture 25 page 144
Plague (Yersinia pestis) and Y. enterocolitica USMLE Step 1 2021 Microbiology lecture 25 page 144 Plague 101 | National Geographic
Plague 101 | National Geographic